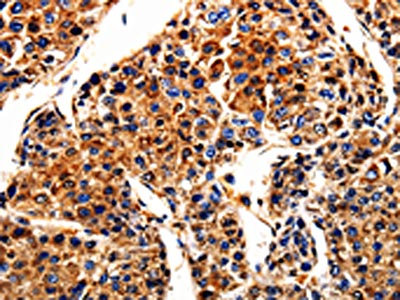

APLP1 Antibody
-
中文名稱:APLP1兔多克隆抗體
-
貨號:CSB-PA828204
-
規格:¥1100
-
圖片:
-
The image is immunohistochemistry of paraffin-embedded Human breast cancer tissue using CSB-PA828204(APLP1 Antibody) at dilution 1/10. (Original magnification: ×200)
-
The image is immunohistochemistry of paraffin-embedded Human liver cancer tissue using CSB-PA828204(APLP1 Antibody) at dilution 1/10. (Original magnification: ×200)
-
Gel: 8%SDS-PAGE, Lysate: 40 μg, Lane: Human fetal brain tissue, Primary antibody: CSB-PA828204(APLP1 Antibody) at dilution 1/650, Secondary antibody: Goat anti rabbit IgG at 1/8000 dilution, Exposure time: 10 seconds
-
-
其他:
產品詳情
-
Uniprot No.:
-
基因名:APLP1
-
別名:APLP1; Amyloid beta precursor like protein 1; Amyloid beta; A4 precursor-like protein 1; Amyloid-like protein 1; APLP; APLP-1
-
宿主:Rabbit
-
反應種屬:Human,Mouse
-
免疫原:Fusion protein of Human APLP1
-
免疫原種屬:Homo sapiens (Human)
-
標記方式:Non-conjugated
-
抗體亞型:IgG
-
純化方式:Antigen affinity purification
-
濃度:It differs from different batches. Please contact us to confirm it.
-
保存緩沖液:-20°C, pH7.4 PBS, 0.05% NaN3, 40% Glycerol
-
產品提供形式:Liquid
-
應用范圍:ELISA,WB,IHC
-
推薦稀釋比:
Application Recommended Dilution ELISA 1:500-1:5000 WB 1:500-1:2000 IHC 1:10-1:50 -
Protocols:
-
儲存條件:Upon receipt, store at -20°C or -80°C. Avoid repeated freeze.
-
貨期:Basically, we can dispatch the products out in 1-3 working days after receiving your orders. Delivery time maybe differs from different purchasing way or location, please kindly consult your local distributors for specific delivery time.
-
用途:For Research Use Only. Not for use in diagnostic or therapeutic procedures.
相關產品
靶點詳情
-
功能:May play a role in postsynaptic function. The C-terminal gamma-secretase processed fragment, ALID1, activates transcription activation through APBB1 (Fe65) binding. Couples to JIP signal transduction through C-terminal binding. May interact with cellular G-protein signaling pathways. Can regulate neurite outgrowth through binding to components of the extracellular matrix such as heparin and collagen I.; The gamma-CTF peptide, C30, is a potent enhancer of neuronal apoptosis.
-
基因功能參考文獻:
- The direct cleavage of APLP1 is a novel feature of the gamma-secretase. PMID: 29382944
- Results provide direct evidence that APLP1 functions as a neuronal zinc-dependent adhesion protein and allow a more detailed understanding of the molecular mechanisms driving the formation of APLP1 adhesion platforms. PMID: 29021345
- The results show that in cognitively normal young adults carrying APlp1 mutations showed different spontaneous brain activity patterns without cerebral structural differences. PMID: 28987665
- These data reveal a conserved mechanism for the binding of APP-family proteins to HS and imply a specific regulatory role of HS modifications in the biology of APP and APP-like proteins. PMID: 25760599
- APLP1 and APLP2, behave similarly to APP in that they both associate with assembled NMDA receptors in the endoplasmic reticulum PMID: 25683482
- CSF levels of 3 endogenous peptides derived from APLP1 (APL1beta25, APL1beta27 and APL1beta28) were decreased in Down syndrome. PMID: 24740518
- APLP1 has a regulatory role in the nuclear translocation of APP family intracellular domains due to the sequestration of Fe65. PMID: 23874953
- [review] APP and its mammalian homologs, amyloid precursor-like proteins APLP1 and APLP2, participate under physiological conditions via trans-cellular dimerization in synaptogenesis. PMID: 21952790
- APLP1 binds the II-III loop of the Ca(v)2.3 calcium channel and that this binding promotes internalization of the channel. PMID: 22178872
- Both APLP1 and APLP2, form transcriptionally active triple protein complexes with Mint3 and transcriptional co-activators Taz andYap. PMID: 21178287
- The 2.1 A resolution electron density map reveals phosphate ions that are bound to the protein surface. Mutational analysis shows that protein residues interacting with the phosphate ions are also involved in heparin binding. PMID: 21574595
- Human cerebrospinal fluid contains three APLP1-derived Abeta-like peptides that are generated by beta- and gamma-cleavages at a concentration of approximately 4.5 nM. PMID: 20049724
- APLP1 and APLP2 are processed by the gamma-secretase in a Presenilin 1-dependent manner and the extreme carboxyl-terminal fragments produced by this processing (APP-like Intracellular Domain) are able to enhance Fe65-dependent gene activation PMID: 12228233
- APLP1 does not undergo the same type of regulated processing as APP and APLP2. PMID: 14597230
- APLP1 and APLP2 and APP are processed similarly to act via the same nuclear target and are regulated by BACE 1 in neurons PMID: 14699153
- APLP-1 and APLP-2 are processed by alpha- and gamma-secretase-like cleavages, and their intracellular domains can be released by cleavage at epsilon-sites. APLP-2 processing appears to be the most elaborate and to involve alternative cleavage sites. PMID: 14970212
- The 5' UTR of the Aplp1 gene lacks any type of CAGA box. This may explain its inability to form amyloid plaques. PMID: 15208260
- APLP1 affects the endocytosis of APP and makes more APP available for alpha-secretase cleavage PMID: 16344553
- APLP1 is differentially upregulated in gastrointestinal neuroendocrine tumours and may be important for the dissemination of small intestinal carcinoids PMID: 18430897
- Coexpression of APP with APLP1 or APLP2 leads to diminished generation of Abeta42 PMID: 19126676
- neither cell-derived nor chemically synthesized APLP1-derived peptide influences the oligomerization or aggregation of Abeta PMID: 19401174
顯示更多
收起更多
-
亞細胞定位:Cell membrane; Single-pass type I membrane protein.; [C30]: Cytoplasm. Note=C-terminally processed in the Golgi complex.
-
蛋白家族:APP family
-
組織特異性:Expressed in the cerebral cortex where it is localized to the postsynaptic density (PSD).
-
數據庫鏈接:
Most popular with customers
-
-
YWHAB Recombinant Monoclonal Antibody
Applications: ELISA, WB, IHC, IF, FC
Species Reactivity: Human, Mouse, Rat
-
Phospho-YAP1 (S127) Recombinant Monoclonal Antibody
Applications: ELISA, WB, IHC
Species Reactivity: Human
-
-
-
-
-